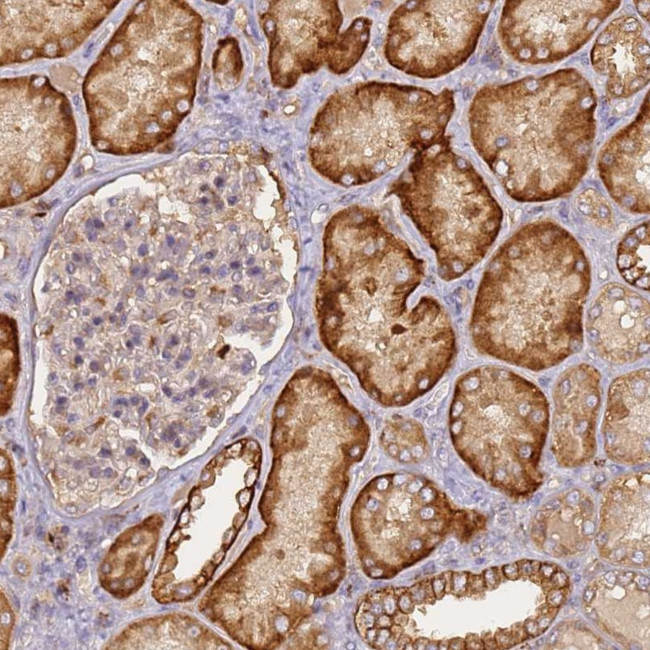
M6PR Antibody in Immunohistochemistry (Paraffin) (IHC (P))

Search
Invitrogen
M6PR Polyclonal Antibody
{{$productOrderCtrl.translations['antibody.pdp.commerceCard.promotion.promotions']}}
{{$productOrderCtrl.translations['antibody.pdp.commerceCard.promotion.viewpromo']}}
{{$productOrderCtrl.translations['antibody.pdp.commerceCard.promotion.promocode']}}: {{promo.promoCode}} {{promo.promoTitle}} {{promo.promoDescription}}. {{$productOrderCtrl.translations['antibody.pdp.commerceCard.promotion.learnmore']}}
产品信息
PA5-111123
种属反应
宿主/亚型
分类
类型
抗原
偶联物
形式
浓度
规格
纯化类型
保存液
内含物
保存条件
运输条件
RRID
产品详细信息
Immunogen sequence: VKRLKPLFNK SFESTVGQGS DTYIYIFRVC REAGNHTSGA GLVQINKSNG KETVVGRLNE THIFNGSNWI MLIYKGGDEY DNHCGKEQRR AVVMISCNRH TLADNFNPVS EERGKVQDCF YLFE
Highest antigen sequence indentity to the following orthologs: Mouse - 93%, Rat - 93%.
靶标信息
M6PR is a receptor for mannose-6-phosphate groups on lysosomal enzymes. The receptor forms a homodimer or homotetramer for intracellular targeting of lysosomal enzymes and export of newly synthesized lysosomal enzymes into the cell secretions. The receptor is an integral membrane protein which localizes to the trans-Golgi reticulum, endosomes, and the plasma membrane.
仅用于科研。不用于诊断过程。未经明确授权不得转售。
生物信息学
蛋白别名: 46 kDa mannose 6-phosphate receptor; 46-kDa mannose 6-phosphate receptor; Cation-dependent mannose-6-phosphate receptor; CD Man-6-P receptor; FLJ32994; M6PR; mannose 6-phosphate-specific receptor protein precursor; MPR 46; Mr 46,000 Man6PR; small mannose 6-phosphate receptor; unnamed protein product
基因别名: CD-M6PR; CD-MPR; M6PR; MPR 46; MPR-46; MPR46; MPRD; SMPR
UniProt ID: (Human) P20645
Entrez Gene ID: (Human) 4074